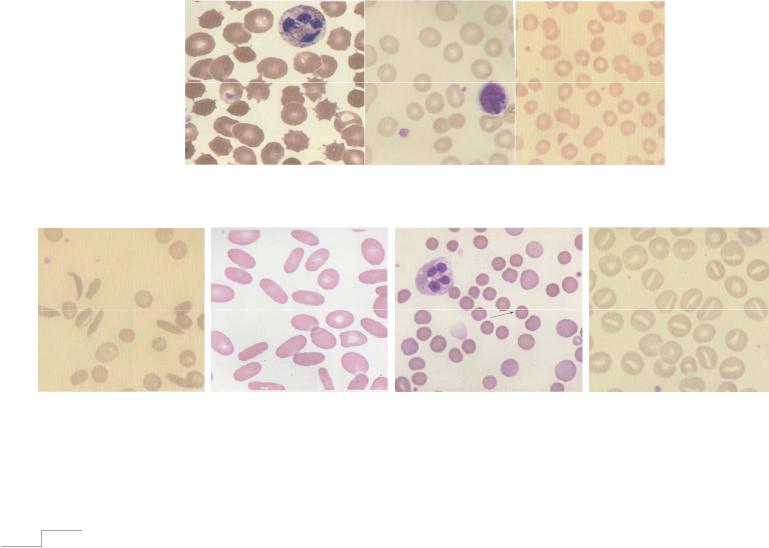
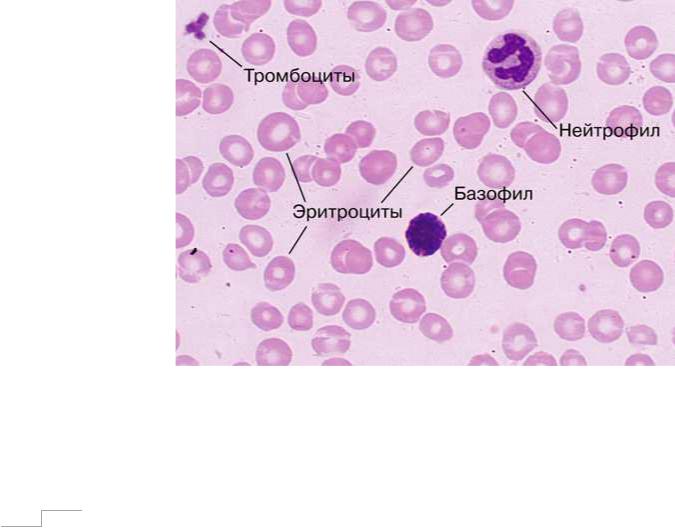

Материал: blood4
МАРКОВЦЕВА М.В.
АНЕМИЧЕСКИЙ СИНДРОМ В КЛИНИЧЕСКОЙ ПРАКТИКЕ Учебно-методическое пособие для студентов,
интернов, ординаторов
0 

Издается по решению Ученого совета Института медицины, экологии и физической культуры Ульяновского государственного университета
Рецензент – кандидат медицинских наук, доцент Черданцев Александр Петрович
Марковцева М.В.
Анемический синдром в клинической практике.
Электронное учебно-методическое пособие содержит подробное изложение наиболее часто встречающихся в практике анемий, представленных в рамках дифференциальной диагностики по цветовому показателю. В работе отражены алгоритмы диагностического поиска, оптимизация выбора лечения, возрастные особенности 10 нозологических форм. Учебнометодическое пособие предназначено для студентов старших курсов медицинских ВУЗов, интернов, ординаторов, практикующих врачей – терапевтов, врачей общей практики, а также врачей других специализаций, занимающихся вопросами диагностики и лечения анемий.
1 

Содержание
I.Феномен анемического синдрома………………………………………… 3
Контрольные задания к разделу I………………………………………..8
II.Гипохромные анемии…………………………………………………..........9 II.1 Железодефицитная анемия……………………………………………9
Контрольные задания к разделу II.1 …………………………………….25
II.2 Анемия при хронических заболеваниях……………………………...28 Контрольные задания к разделу II.2……………………………………..30
II.3 Талассемия…………………………………………………………....32
Контрольные задания к разделу II.3……………………………………37
II.4 Сидеробластные анемии…………………………………………….38
Контрольные задания к разделу II.4………………………………………..40
Алгоритм диагностического поиска при выявлении гипохромной гипорегенераторной анемии…………………………………………………….42
III Нормохромные анемии………………………………………………………44
III.1 Острая постгеморрагическая анемия……………………………….44
Контрольные задания к разделу III.1………………………………………46 III.2 Гемолитические анемии………………………………………………47
Контрольные задания к разделу III.2………………………………………55
III. 3 Апластическая анемия………………………………………………...58
Контрольные задания к разделу III.3……………………………………….63
III. 4 Анемия при хронической почечной недостаточности…………….64
Контрольные задания к разделу III.4……………………………..……....67
Алгоритм диагностического поиска при выявлении нормохромной норморегенераторной анемии…………………………………………………..68
IV. Гиперхромные анемии………………………………………………………70
IV.1 В12-дефицитная анемия……………………………………………….70
Контрольные задания к разделу IV.1……………………………………….79
IV.2 Фолиеводефицитная анемия…………………………………………...81
Контрольные задания к разделу IV.2………………………………………..83
Алгоритм диагностического поиска при выявлении гиперхромной гипорегенераторной анемии…………………………………………………….84
Список рекомендуемой литературы……………………………………………85
2
I Феномен анемического синдрома
Анемический синдром является самым распространенным проявлением гематологической патологии и включает в себя совокупность лабораторных и клинических признаков. К первым относится снижение количества эритроцитов и\или гемоглобина в единице объема крови. Количество эритроцитов менее 3,8*1012/л и гемоглобина менее 115 г/л для женщин,
количество эритроцитов менее 4,15*1012/л и гемоглобина менее 130 г/л для мужчин расцениваются на сегодняшний день как анемия. Представленные гендерные различия содержания количества гемоглобина и эритроцитов обусловлены более высоким уровнем у мужчин андрогенов, которые, как известно, обладают стимулирующим воздействием на эритропоэз.
Рисунок 1. Мазок нормальной крови.
3 

Взависимости от уровня гемоглобина выделяют 3 степени тяжести анемии:
-легкая степень – уровень гемоглобина выше 90 г/л;
-средняя степень – уровень гемоглобина 70-89 г/л;
-тяжелая степень – уровень гемоглобина ниже 70 г/л.
По количеству гемоглобина в эритроците анемии подразделяют на:
- гиперхромные – цветовой показатель1 более 1,05; МСН2 более 32,0
пг; МСНС3 более 36,0 г/ дл; - нормохромные – цветовой показатель 0,85 – 1,05, МСН 27,0-32,0
пг; МСНС 32,0-36,0 г/ дл; - гипохромные – цветовой показатель менее 0,85; МСН менее 27,0
пг; МСНС менее 32,0 г/ дл.
По размерам эритроцитов анемии подразделяют на:
- микроцитарные – размер эритроцита 5,0-6,5 мкм; MCV4 менее 77
фл;
-нормоцитарные – размер эритроцита 7-7,55 мкм; MCV 77-95 фл;
-макроцитарные – размер эритроцита 8-10 мкм; MCV более 95 фл;
-мегалоцитарные – размер эритроцита 11-12 мкм.
1Цветовой показатель (ЦП) - параметр, выражающий относительное содержание гемоглобина в одном эритроците, выраженное во внесистемных единицах. Рассчитывается по формуле:
,где Hb – содержание гемоглобина в г/л
2МСН – среднее содержание гемоглобина в эритроците, пг (пикограмм).
Рассчитывается по формуле: , где Hb – содержание гемоглобина в г/л, В –
число эритроцитов в 1 л . MCH можно получить при умножении параметра цветового показателя на коэффициент 33,3.
3МСНС – средняя концентрация гемоглобина в эритроците. Рассчитывается по формуле:
,где Hb – содержание гемоглобина в г/л, Ht – гематокрит в %.
4MCV – средний объем эритроцита, фл (фентолитр). Рассчитывается по формуле:
,где Ht – гематокрит в %, эритроциты - х*1012/л .
4